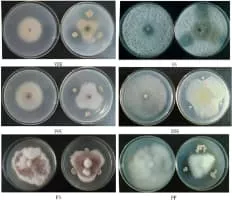

Bacillus Amyloliquefaciens
| Use attributes for filter ! | |
| Scientific name | Bacillus amyloliquefaciens |
|---|---|
| Higher classification | Bacillus |
| Rank | Species |
| Family | Bacillaceae |
| Class | Bacilli |
| Phylum | Firmicutes |
| Date of Reg. | |
| Date of Upd. | |
| ID | 1176267 |
About Bacillus Amyloliquefaciens
Bacillus amyloliquefaciens is a species of bacterium in the genus Bacillus that is the source of the BamHI restriction enzyme.